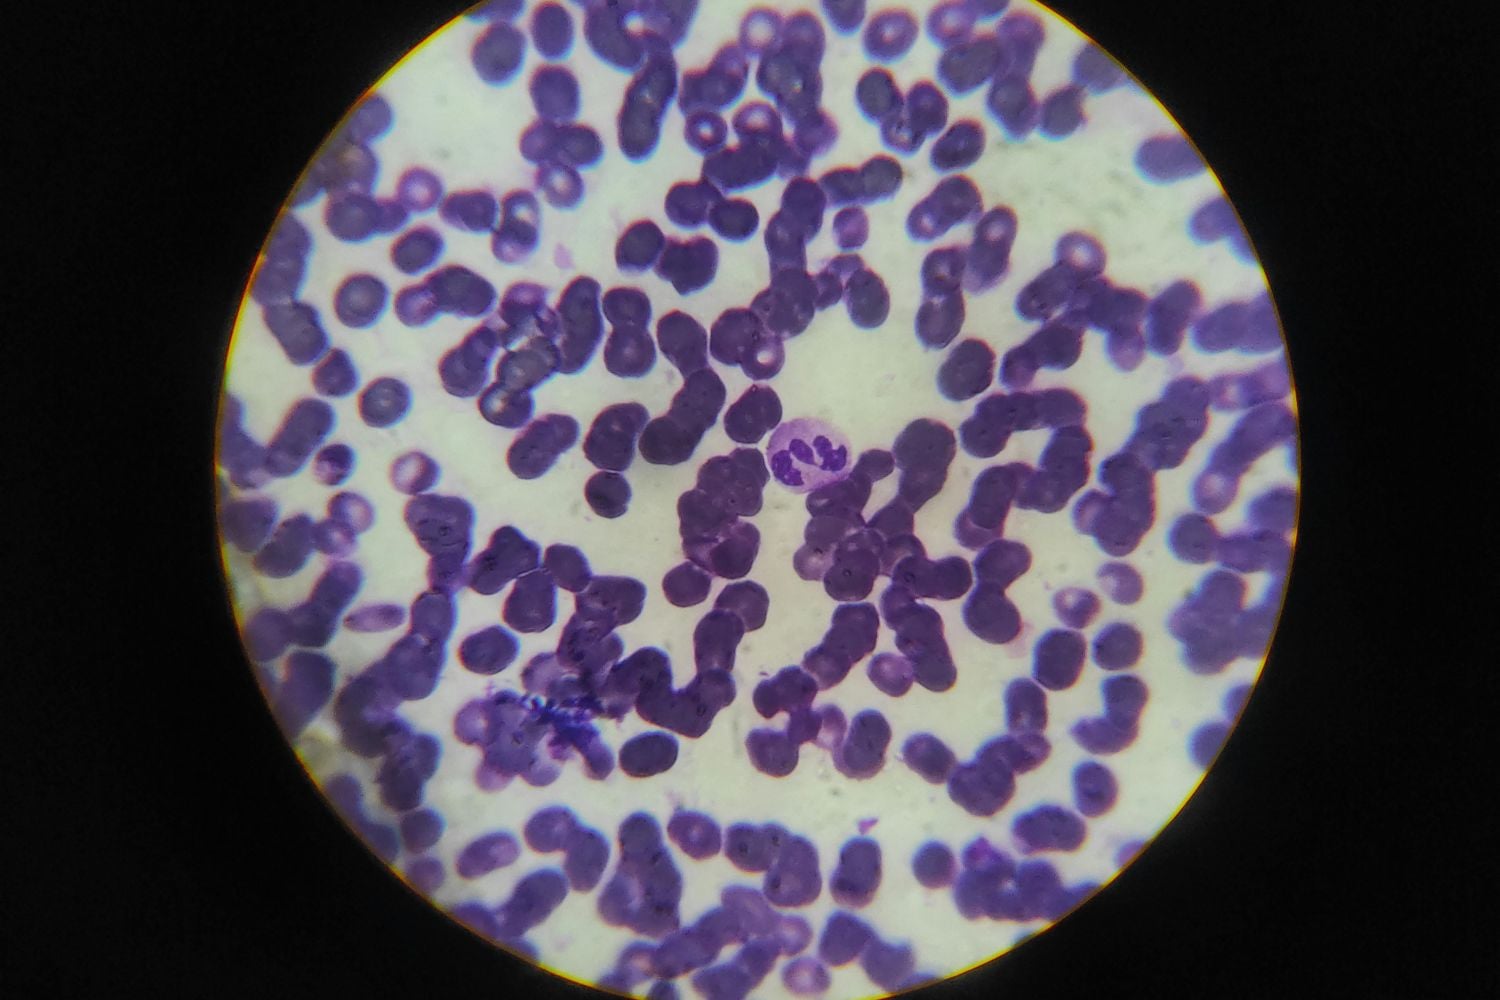
Diseño Sin Título 2026 04 11t213718.455

Durante años, la ciencia ha intentado descifrar los secretos del embarazo, un proceso tan común como complejo. Sin embargo, incluso en este terreno ampliamente estudiado, siguen apareciendo hallazgos sorprendentes. Un reciente descubrimiento ha revelado la existencia de un elemento desconocido que actúa en uno de los momentos más críticos del desarrollo. Su comportamiento plantea nuevas preguntas y podría abrir caminos inesperados en la comprensión de la gestación.
Un nuevo actor en un proceso cuidadosamente equilibrado
El embarazo ha sido descrito durante décadas como una interacción constante entre el organismo materno y el fetal. Lejos de ser un proceso pasivo, implica una coordinación precisa de señales químicas, respuestas inmunológicas y transformaciones estructurales. En este delicado equilibrio, cada componente cumple una función específica para asegurar el desarrollo adecuado del embrión.
En este contexto, un estudio reciente publicado en la prestigiosa revista Nature ha añadido una pieza completamente inesperada al rompecabezas. Investigadores identificaron un tipo de célula que no había sido descrito anteriormente y que, sorprendentemente, solo aparece durante el embarazo.
Este hallazgo no solo amplía el conocimiento sobre la biología reproductiva, sino que también sugiere que aún existen aspectos fundamentales del cuerpo humano que permanecen ocultos.
Un mapa celular que reveló lo inesperado
El descubrimiento forma parte de un ambicioso proyecto científico que busca cartografiar con precisión la llamada interfaz materno-fetal, el punto donde el tejido del embrión se conecta con el útero para formar la placenta.
El equipo de investigación, liderado por Susan Fisher, analizó más de un millón de células individuales. Este enfoque permitió no solo identificar qué genes están activos en cada célula, sino también comprender su ubicación y su interacción dentro del tejido.
Fue en medio de este análisis detallado donde surgió la sorpresa: una población celular que no coincidía con ninguna clasificación conocida. No estaba presente fuera del embarazo ni correspondía a ningún tipo previamente documentado.
Aparece en las primeras etapas de la gestación y desaparece posteriormente, como si su existencia estuviera estrictamente limitada a ese momento específico. Incluso expertos consultados por el equipo reconocieron no haber visto algo similar antes.
Un regulador en una frontera crítica
Más allá de su existencia, lo que realmente intriga a los científicos es la función de estas células. Todo apunta a que se ubican en la primera línea de contacto entre madre y feto, una zona clave donde las células embrionarias comienzan a invadir el tejido uterino para establecer el suministro sanguíneo necesario para la placenta.
Este proceso debe mantenerse en un equilibrio extremadamente preciso. Si la invasión es insuficiente, pueden surgir complicaciones como la preeclampsia. Por el contrario, si es excesiva, puede derivar en condiciones graves como la placenta accreta.
Aquí es donde estas nuevas células parecen desempeñar un papel crucial. Actúan como una especie de regulador biológico, una barrera dinámica que controla cuánto y cómo avanzan las células fetales en el tejido materno. No bloquean el proceso, pero lo moderan lo suficiente como para mantenerlo dentro de límites seguros.
Una reacción inesperada ante ciertos compuestos
Uno de los aspectos más llamativos del estudio tiene que ver con la respuesta de estas células a la exposición a moléculas externas, en particular aquellas relacionadas con los cannabinoides.
Los investigadores observaron que, al entrar en contacto con estos compuestos (como los presentes en el cannabis), estas células aumentaban su capacidad de restricción sobre la invasión placentaria. Este comportamiento no ofrece una explicación definitiva, pero sí abre una nueva línea de investigación.
Podría ayudar a entender por qué el consumo de estas sustancias durante el embarazo se ha asociado con efectos como bajo peso al nacer, partos prematuros o alteraciones en el desarrollo de la placenta. Más que una conclusión cerrada, se trata de una pista que invita a profundizar en la relación entre factores externos y procesos biológicos internos.
Un recordatorio de lo que aún no sabemos
Este descubrimiento refuerza una idea que gana cada vez más fuerza en la comunidad científica: el embarazo no es un proceso uniforme ni completamente comprendido. Es un sistema dinámico, en el que distintos tipos celulares aparecen, se transforman y desaparecen en cuestión de semanas.
La existencia de esta nueva célula sugiere que el cuerpo humano sigue guardando secretos, incluso en procesos que han sido estudiados durante siglos. Lejos de ser un sistema completamente cartografiado, sigue siendo un territorio en expansión, donde cada hallazgo abre nuevas preguntas.
Y quizá lo más fascinante de todo es que, en medio de lo que creemos conocer, todavía hay piezas invisibles que sostienen el equilibrio de la vida sin que siquiera sepamos que están ahí.
[Fuente: La Razón]